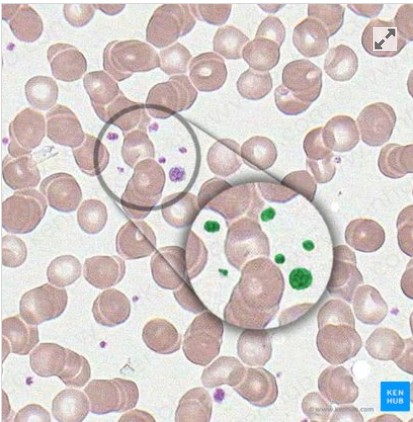
term image
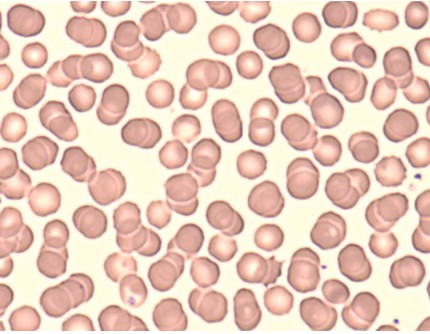
term image
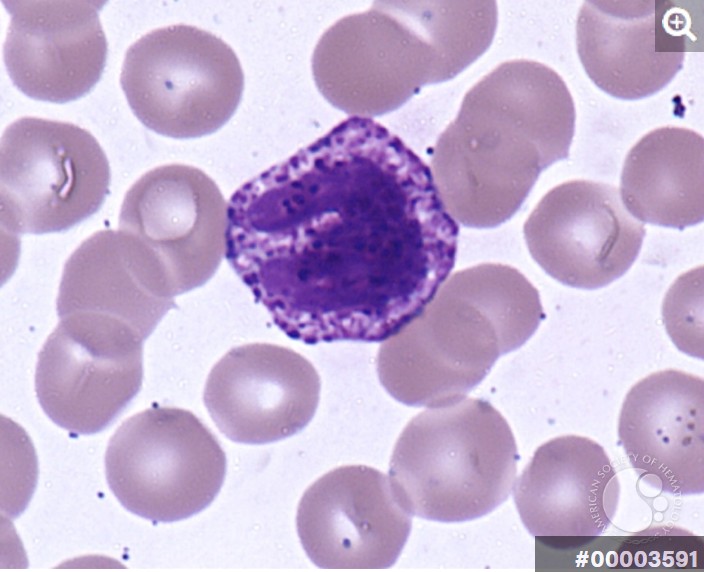
term image
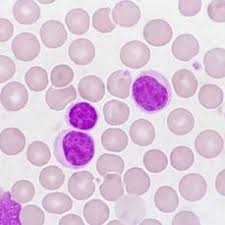
term image
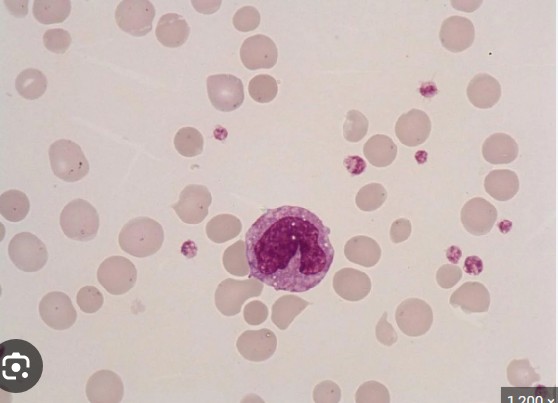
term image

1/122
Looks like no tags are added yet.
Name | Mastery | Learn | Test | Matching | Spaced | Call with Kai |
|---|
No analytics yet
Send a link to your students to track their progress
Abdominal Cavity
Liver, stomach
Thoracic Cavity
lungs, heart
Cranial Cavity
brain
vertebral cavity
spinal cord

Corona/frontal plane

Sagittal/Median plane

Transverse plane
Right Upper Abdominal Quadrant
Liver, gallbladder
Left Upper Abdominal Quadrant
Spleen, Pancreas
Right Lower Abdominal Quadrant
Appendix, small intestine
Left Lower Abdominal quadrant
large intestine, small intestine
Neutral Ph
7
Acidic Ph
Below 7
Basic Ph
Above 7
Neutralizing vs Buffering
Neutralizing is a chemical reaction that combines an acid and base to create a neutral salt and water. Buffering uses a weak acid and its conjugate base to resist drastic changes when small amounts of acid or base are added, maintaining a stable range rather than making it neutral.

Hypothalamus

Infundibulum

Pituitary gland

Pineal Gland

Parathyroid gland

Thymus gland

Adrenal/suprarenal glands |

Adrenal/suprarenal cortex

Adrenal/suprarenal medulla

Pancreas
Ovaries Hormones |
estrogen, progesterone
Testes Hormones
Testosterone
Pancreas and Pancreatic Islets hormones
Insulin and Glucagon
Adrenal medulla
Epinephrine and Norepinephrine
Adrenal cortex
cortisol, aldosterone
Thymus gland hormones |
thymosin, thymopoetin
Parathyroid glands hormones |
Parathyroid hormone (PTH)
Thyroid Gland Hormones
T3, T4, and Calcitonin
Pineal gland Hormones |
Melatonin
Posterior pituitary hormones |
Oxytocin, Antidiuretic hormone (ADH)
anterior pituitary hormones |
Growth Hormone (GH), Thyroid-Stimulating Hormone (TSH), Adrenocorticotropic Hormone (ACTH), Follicle-Stimulating Hormone (FSH), Luteinizing Hormone (LH), and Prolactin (PRL).
Hypothalamus hormones
all “releasing” hormones
Insulin
Released by beta cells, lowers blood sugar by facilitating cellular uptake of glucose
Glucagon
Released by alpha cells. Increases blood sugar by stimulating the liver to release glucose in the blood.
transport of hormones from the hypothalamus to the posterior pituitary
Hormones (oxytocin and ADH/vasopressin) are synthesized in the hypothalamic nuclei, packed into secretory vesicles, and transported via axonal transport down the hypothalamic-hypophyseal tract through the infundibulum. These hormones are stored in axon terminals called Herring bodies in the posterior pituitary until neural signals trigger their release into the bloodstream.
transport of hormones from the hypothalamus to the anterior pituitary
Hormones are transported from the hypothalamus to the anterior pituitary via the hypophyseal portal system, a specialized network of blood vessels.
Thrombocytes (platelets)
Erythrocytes
Basophils

Eosinophils
Lymphocytes
Monocytes

Neutrophils

Visceral Pericardium (epicardium) |

Myocardium

Endocardium

Left Auricle

Ligamentum arteriosum

Right auricle

Aortic (semilunar) Valve |

Bicuspid (mitral valve or left atrioventricular) Valve |

Interventricular Septum |

Papillary Muscles |

Pulmonary (semilunar) Valve |

Tricuspid (Right AV) Valve |

Anterior Interventricular Artery (branch) |

Circumflex artery (branch)

Great Cardiac Vein |

Left Coronary Artery

Right coronary artery

Marginal branches

Coronary sinus

Posterior interventricular branch/artery

Brachiocephalic trunk (artery)

Left common carotid artery

Left subclavian artery

Left pulmonary artery

left pulmonary veins

right pulmonary veins

Sinoatrial (SA) Node

Atrioventricular (AV) node

Left bundle brances

right bundle branches

Purkinje fibers
S1 “Lub”
Closure of both AV Valves
S2 “Dub”
Closure of both semilunar valves
S1 “Lub” Auscultation Location
The apex of the heart, specifically at the left 5th intercostal space
S2 “Dub” Auscultation Location
The base of the heart, specifically the second intercostal space at the right upper sternal border

Right common carotid artery

Left common carotid artery

Internal jugular vein

Right subclavian artery

Left subclavian artery

Left subclavian vein

Left brachiocephalic vein

Celiac trunk

left common iliac artery

Left common iliac vein

Left external iliac artery

Left external iliac vein

common hepatic artery

Inferior mesenteric artery

Superior mesenteric artery

Right renal artery

right renal vein